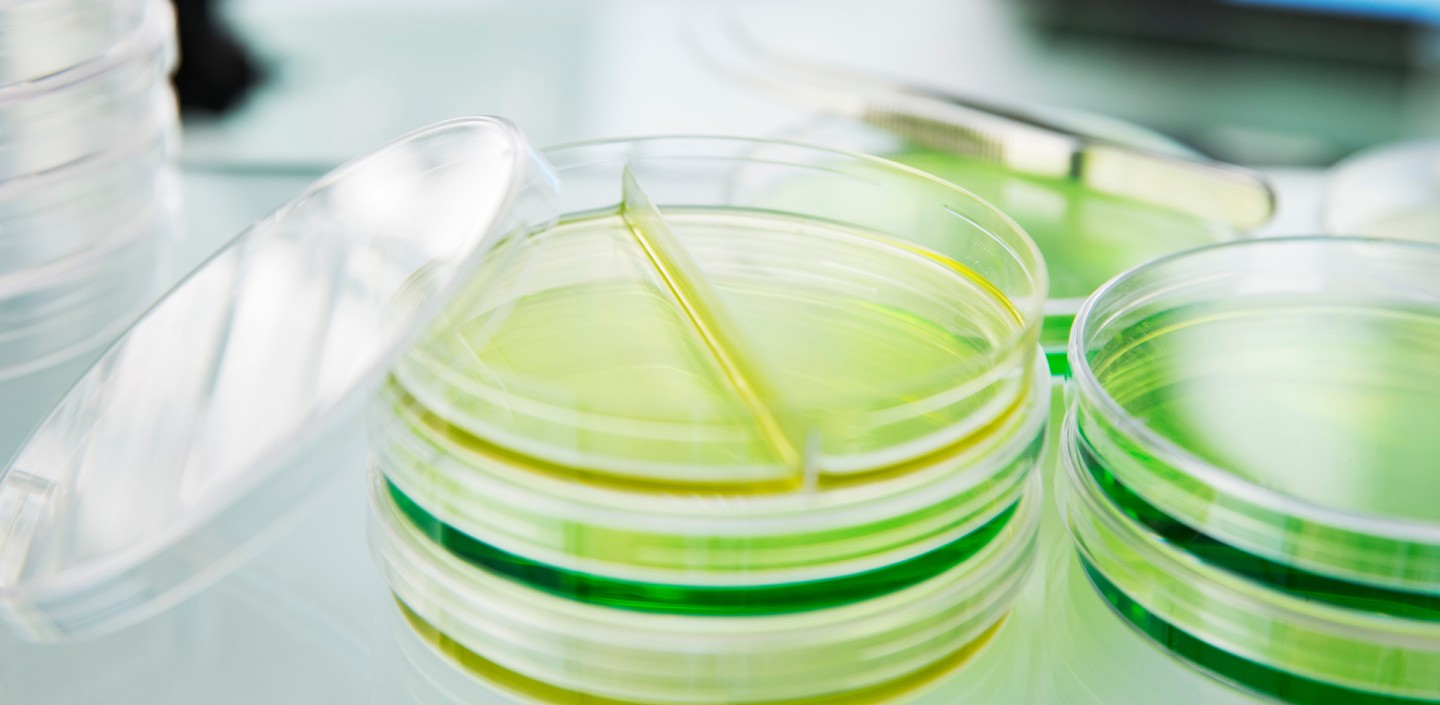
Stack of Petri dishes in a lab

Frequently Asked Questions
I am having a problem accessing the course. What should I do?
Please contact Nancy Long (ifstraining [at] cornell.edu (ifstraining[at]cornell[dot]edu)) and she will assist you with gaining access to the course.
Is the course offered in Spanish?
Unfortunately at this time, we do not offer the Food Microbiology Fundamentals course in Spanish.
I completed the course. How can I get my Certificate of Completion?
Certificates of Completion are issued weekly on Friday mornings during business operations. For questions, please contact Nancy Long (ifstraining [at] cornell.edu (ifstraining[at]cornell[dot]edu)). Please note, we sometimes adjust the schedule for University or office closures, but will give enrolled participants advanced notice through announcements in Canvas.
May I have an extension to complete the course?
Participants have 5 weeks to complete the course from the time of payment. If you need additional time to complete the course, please email Nancy Long (ifstraining [at] cornell.edu (ifstraining[at]cornell[dot]edu)) to request a one-time extension. Please note that we do not grant participants unlimited access to the course.
I paid for the course, but now I don’t need to take it. How do I get a refund for the course?
Unfortunately, refunds are not available after payment for the course is received.
How do I know if I completed all the quizzes for each module?
You can select “Grades” from the menu bar in Canvas. It will bring up a window that shows your grade for each assignment quiz. If you are missing a grade, then you have not submitted a quiz for that section. You can go back to the course module and submit the assignment quiz.
You must complete and submit all assignment quizzes for each module with a passing score of 100% to complete the course.
How do I download PDFs of the training modules?
Unfortunately, it is not possible to download the training modules as a single PDF.
How do I access the links/resources provided in the course?
All of the links/resources shared within the course are available on the IFS@CU’s website, under Course Resources on the Food Microbiology Fundamentals course web page.